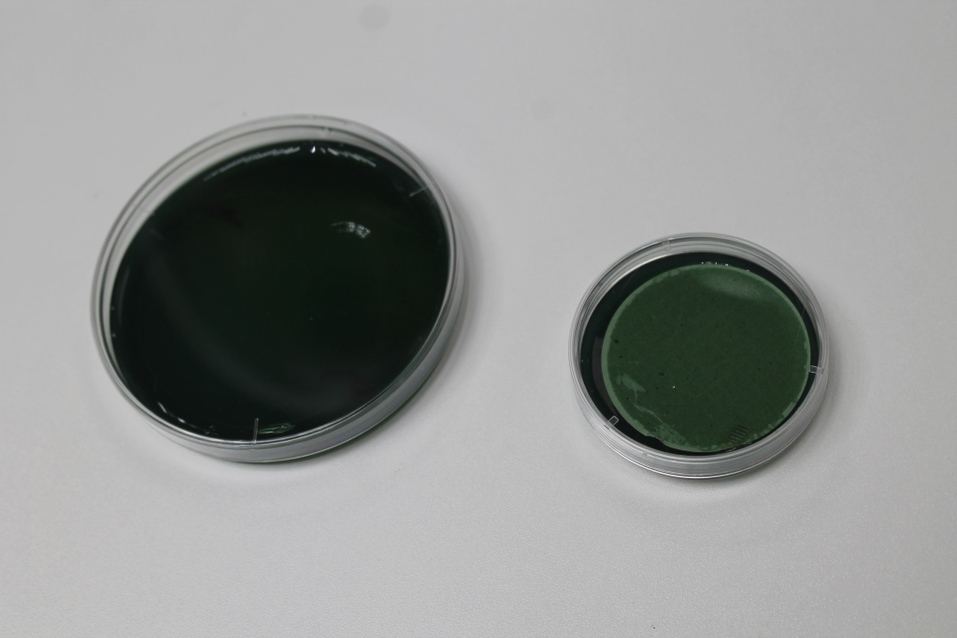
День на производстве: «ДК» узнал, как варят пиво «Балтика» в Новосибирске 12 День на производстве: «ДК» узнал, как варят пиво «Балтика» в Новосибирске 12

День на производстве: «ДК» узнал, как варят пиво «Балтика» в Новосибирске
Микробиологи, технологи, специалисты по розливу, техническая служба — чтобы сварить пиво, недостаточно одного пивовара. Кто и что стоит за процессом приготовления, казалось бы, простого напитка?
В рамках проекта «День на производстве» ДК посетил с экскурсией* новосибирский пивоваренный завод «Балтика», чтобы выяснить, какие процессы проходит сырье, прежде чем превратиться в пиво.
Проектная мощность завода «Балтика», существующего в Новосибирске с 2008 года, составляет сегодня 4,6 миллиона гектолитров пива в год.
Подготовка и начало приготовления пива
Чтобы сварить пиво, нужно сначала приготовить сусло — это основа, которую варят из дробленого солода, воды и хмеля. Солод — это пророщенное зерно ячменя. Он бывает светлый, золотистый, янтарный или тёмный, что зависит от степени тепловой обработки. Соответственно, цвет пива — это цвет, который дает ему солод. Хмель — это растение, которое нужно пиву для аромата, горечи и пенообразования. Вопреки распространенному мнению, хмель не дает градус — этим занимаются дрожжи.
Ведущий технолог цеха пивопроизводства новосибирского завода «Балтика» Наталья Шицко подробно рассказала ДК о том, как варится пиво, и какой вклад вносит в этот процесс каждый из ингредиентов.
— Начинается все с поступления на завод солода, который размещается на элеваторе. Затем он передается в отделение подработки, в котором работает несколько единиц оборудования, позволяющего очистить зерно от пыли и примесей. После этого запускается процесс дробления зерна буквально «в муку».
Измельченный солод после стадии дробления переходит в варочный цех, где независимо друг от друга работают два варочных порядка — это нужно для производительности и для того, чтобы максимально гибко подходить к производству в высокие и низкие сезоны: летом работает два порядка, зимой — один.
В каждом порядке — по два заторных котла. В них происходит процесс затирания: дробленый солод смешивается с водой, нагревается до определенных температур, при которых выдерживается некоторое время. Стандартные температуры — 52, 62, 72 и 78 градусов. Мы подбираем процесс затирания в зависимости от того, какой продукт хотим получить: все зависит от рецепта. Во время выдержки на каждой температуре из зерна «вытягивается» в раствор определенный фермент: когда зерно раздроблено, ферменты начинают работать на расщепление крупных молекул, находящихся в зерне (крахмала, белков) на маленькие кусочки, которыми впоследствии будут питаться дрожжи в процессе брожения.
Поэтому очень важно, чтобы температуры и время выдержки были выставлены строго в соответствии с рецептом. За этим следят пивовары с помощью специального автоматизированного оборудования, в программе которого прописаны все требования рецептур. На каждой единице оборудования, участвующего в процессе производства, есть температурные датчики, которые каждые 2-5 секунд ведут замер температуры в той среде, в которой они находятся, и передают информацию на компьютер. На экране операторов, следящих за процессом через компьютер, прорисованы все котлы, трубопроводы, клапаны. Датчик обязательно реагирует на малейшие изменения и передает сигнал в случае, если температура отступает от рецепта. Об этом сразу оповещается техническая служба, которая ищет и устраняет причину изменения температуры.
После завершения процесса затирания (то есть, когда все крупные молекулы растительных белков расщеплены), затор уходит на следующий этап, где происходит фильтрация.
На большинстве пивоваренных заводов для этого используются фильтр-чаны, то есть аппараты с двойным дном: нижнее дно — цельное, верхнее — с отверстиями. Затор перекачивается туда, ему дается время на расслоение, чтобы дробина (то есть крупные части) осела, а жидкость (сусло) осталась наверху. После этого начинается процесс фильтрации: затор проходит через слой дробины — так сусло становится практически прозрачным. Продолжительность процесса от затирания до выхода готового сусла может составлять от 3 до 7 часов. Все зависит от того, сколько и каких видов солода используется для приготовления конкретного сорта пива. Так, для темных сортов используют и светлый, и карамельный, и жженый солод, что увеличивает количество необходимых пауз при затирании. После фильтрации затора начинается следующий этап производства — кипячение сусла.
Во время кипячения при температуре чуть выше 100 градусов в сусле нейтрализуются остатки растительного белка, это в дальнейшем помогает лучше сохранять пиво. Именно на этой стадии мы добавляем в сусло хмель. Это как раз самый главный ингредиент, который отвечает не только за ароматику, но и за стойкость напитка. Вопреки потребительским мифам, пиву не нужны никакие консерванты, ведь добавление хмеля помогает пиву дольше храниться.
Когда кипячение сусла завершено, оно с большой скоростью перекачивается в специальный котел — это нужно, чтобы белки, находящиеся в зерне, свернулись и осели. Под воздействием центробежных сил они собираются в центре емкости, а после этого их легко отделить от чистого сусла. После перекачки сусла мы даем ему время отстояться, потом постепенно перекачиваем. В момент полной перекачки в центре котла формируется так называемая белковая лепешка, по качеству которой мы можем понять, насколько удачно мы завершили все процессы — она должна быть плотной, скомпонованной четко по центру.
На следующем этапе сусло отправляется в теплообменник, где охлаждается до начальной температуры брожения и уходит в бродильное отделение. Стоит отметить, что мы во всех процессах производства пользуемся только холодной водой, потому что можем нагревать ее сами: когда сусло идет в теплообменник, оно находится через стенку с холодной водой, таким образом, оно остывает, а вода нагревается и идет дальше. Этой горячей водой мы обеспечиваем полностью весь завод.
Дрожжи — отдельный мир
— Для производства пива используются специально изученные и выведенные дрожжи. Существует несколько рас дрожжей, и каждая компания подбирает их под себя индивидуально. У каждой конкретной расы — свои особенности, благодаря которым разные дрожжи выдают пиво определенного «характера»: какие-то — мягкое, с фруктовым ароматом, какие-то — «суховатое», с небольшим количеством побочных продуктов брожения и так далее. Расы дрожжей никогда не смешиваются друг с другом – это недопустимо.
Впервые чистая культура пивоваренных дрожжей была получена в 1881 году сотрудником датской Лаборатории Carlsberg Эмилем Кристианом Хансеном. А спустя 2 года он успешно использовал ее для производства пива. Весь современный пивоваренный процесс был определен этим открытием, в том числе потому, что основатель компании Carlsberg, частью которой сегодня является «Балтика», безвозмездно поделился чистой культурой дрожжей с пивоварами многих стран. До этого момента использовались «дикие» дрожжи, процесс брожения с которыми был неконтролируемым.
Как происходит процесс брожения? В специальные цилиндро-конические танки (ЦКТ) задается холодное сусло и дрожжи. Так запускается процесс брожения, во время которого дрожжи потребляют содержащиеся в сусле натуральные сахара, полученные из солода, и образуют углекислоту и спирт. Помимо этого, в ходе брожения образуется огромное количество так называемых вкусо-ароматических соединений, которые в конечном итоге и формируют букет готового пива. Во время брожения температура в танках довольно высока, и, если ее не контролировать, она может подняться на недопустимый уровень. Чтобы этого не происходило, внутри каждой емкости стоят датчики, которые «знают», что в каждой рецептуре предусмотрена конкретная температура. Как только она повышается на 0,1-0,2 градуса, датчик передает сигнал на клапаны, которые открываются и выпускают охлаждающий агент. Каждый танк похож на огромный термос — это две стальных емкости, вставленных одна в другую. Между ними по трубопроводам мы и запускаем хладагент, который при необходимости охлаждает пиво в процессе брожения.
На нашем заводе мы производим лагеры — это пиво низового брожения. Поэтому, когда процесс брожения заканчивается, дрожжи оседают на дно, собираются в конической части танка, а потом направляются в один из дрожжесборников. Там они, как любые живые организмы, отдыхают какое-то время, а после того, как «проголодаются», мы задаем их в свежую порцию сусла. Таких оборотов (генераций) у каждой расы дрожжей — индивидуальное количество. Некоторые виды дрожжей могут использоваться не более шести раз, так как они испытывают большой стресс, и через какое-то время начинают разрушаться, тогда их использовать уже нельзя.
Изначально дрожжи приходят на завод в стеклянной пробирке, где налита питательная среда, на поверхности которой «сидит» несколько стерильных дрожжевых клеток. Когда нам нужна очередная партия дрожжей, наша микробиологическая лаборатория выращивает нам к определенной дате нужную нам расу дрожжей. Специалисты лаборатории снимают несколько дрожжевых клеток и помещают их в стерилизованное сусло, в маленькую колбу. Дрожжи начинают активно размножаться, и через некоторое время эта масса переносится в колбу большего объема, где дрожжи опять получают много питания и начинают расти дальше. Затем их помещают в еще бОльшую колбу, а потом — в емкость из нержавеющей стали, похожую на пивную кегу, — она предназначена для транспортировки дрожжей из микробилогоческой лаборатории в бродильное отделение.
После того, как дрожжи поступают на производство, там начинают происходить те же самые процессы, что и в лаборатории, но уже в производственных масштабах. Таким образом, из нескольких клеток мы получаем 12 тонн дрожжей, которые передаются в один из ЦКТ, куда уже подается сусло, и начинается масштабный процесс брожения. Различные расы дрожжей выращиваются от недели до десяти дней. Поэтому мы все просчитываем и готовим заранее.
Фильтрация
— В отделении фильтрации работает две линии. Есть также каскад фильтрации, который помогает удалить из пива остаточные дрожжи, частички хмеля, мелкие части зерна, которые могут остаться после варки — в этом отделении пиво делают абсолютно прозрачным, кристальным. Проходя через стерильный фильтр-картон, пиво освобождается от микрофлоры, которая могла бы навредить напитку во время хранения.
Очень важно, чтобы после фильтрации пиво отстоялось в течение нескольких часов, это называется процессом успокоения. Пиво содержит углекислоту, поэтому нужно, чтобы она пришла в связанное состояние, иначе на розливе пиво будет бурно пениться.
Лаборатория
Начальник производственной лаборатории Ольга Сорокина:
— Лабораторный контроль за производственными процессами мы ведем на всех стадиях: когда поступило сырье, лаборатория проверяет, чтобы оно соответствовало всем заданным параметрам. Мы проверяем зернопродукты на экстрактивность (то есть водорастворимость сухих веществ), влажность. Варим пиво в специальных маленьких чанах (имитирующих производственные), проверяем, какой продукт получается из данного сырья. Также мы дробим зерно, делаем рассев — смотрим, сколько там зерновой примеси (то есть пшеницы в ячмене), проверяем на загрязнения и заражение, смотрим, соответствует ли зерно спецификации компании.
На этапе брожения мы проверяем количество горьких веществ в пиве, показатели экстрактивности, содержания спирта, мутность и прозрачность.
Также контролируем промывку всех емкостей, прошедших один производственный цикл — берем пробу и, удостоверившись, что емкости действительно чистые, даем добро на новый цикл.
Под жестким лабораторным контролем находятся также абсолютно все материалы, которые имеют отношения к упаковке: бутылки, банки, пробки, этикетки, картонные коробки и множество других элементов.
Розлив
Начальник смены цеха розлива Анатолий Бабушкин:
— На нашем заводе установлено 6 линий розлива. Производительность двух ПЭТ-линий составляет 22 тысячи бутылок в час, кеговая линия разливает пиво со скоростью 300 кег в час, линия ПЭТ-кеги — 200 кег в час, мощность линий алюминиевой банки и стеклянной бутылки — 40 тысяч бутылок в час. Прежде чем из нашего цеха выйдет упакованный продукт, бутылки будут досконально проверены: поврежденные бутылки выводятся из линии благодаря датчикам, которые реагируют на испорченное изделие, после чего бутылка отсеивается с линии в специальную емкость. На линии каждая бутылка ополаскивается, затем сушится, после этого наносится этикетка.
Кеги проходят тот же этап, только промывка более жесткая — водой, специальными моющими средствами, снова водой и горячим паром. После розлива кеги взвешиваются на специальных автоматических весах, чтобы отбраковать, снять с линии недолив.
Интересный факт о новосибирском заводе «Балтика»
На котлах в варочном цехе надеты специальные чехлы, которые были изобретены энергетиками завода в Новосибирске: они хорошо удерживают тепло, значительно экономя электроэнергию, которая тратится на нагревание котлов. Новосибирский завод, используя эти чехлы, экономит около 2 млн руб. в год на электроэнергии. Такие чехлы используются не только на котлах, но и на некоторых горячих отрезках труб, чтобы максимально удерживать тепло. После того, как изобретение было внедрено и продемонстрировало свою полезность, его применили на заводах «Балтики» в других городах. Сегодня уже не только «Балтика», но и друге компании начинают использовать такие чехлы.
*Пройти по экскурсионному маршруту на пивоварне «Балтика» в Новосибирске может каждый желающий. Условие одно — все посетители должны быть совершеннолетними. Экскурсии проходят ежедневно по будням.
Фоторепортаж Юлии Катковской